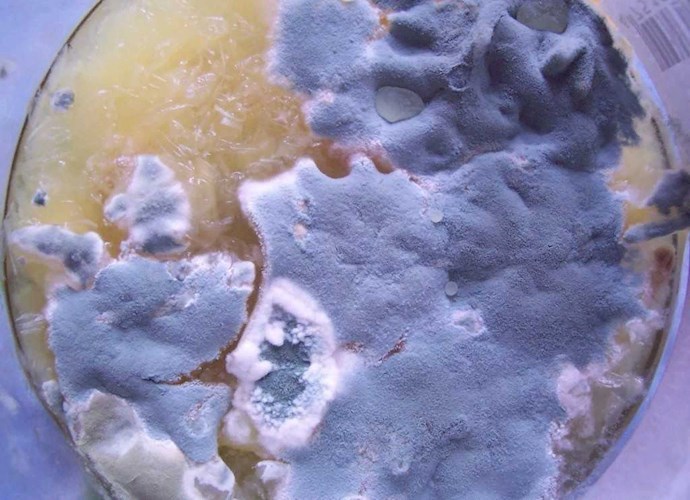
Плесень

Все книги автора Гуляев Александр

Латте с новогодним настроением
Латте с новогодним настроением
Как-то я сильно задержался на работе перед Новым годом, а прохиндей Денис угостил меня кофе...


Конан и череп колдуна
Конан и череп колдуна
Конан получает очередной заказ: украсть у жреца древнего культа необычный камень.

Конан и храм под водой
Конан и храм под водой
Конан получает очередной заказ: надо добыть драгоценную реликвию из древнего храма.

Добрый снеговик
Добрый снеговик
Сказочная история об одном одном снеговике и двух маленьких зайцах


Найти кощея
Найти кощея
Первая история из вселенной Василисы, которая знакомит нас с главной героиней — охотницей за фолькло...

Голова профессора Преображенского
Голова профессора Преображенского
Фантастическая история о живых головах и не только


Новый год с гваа
Новый год с гваа
31 декабря, последние часы перед празднованием Нового года. Но в моём доме возле моего любимого ками...

Холмс против Потрошителя
Холмс против Потрошителя
Кто может поймать неуловимого маньяка, если не знаменитый дуэт с Бейкер-стрит?






